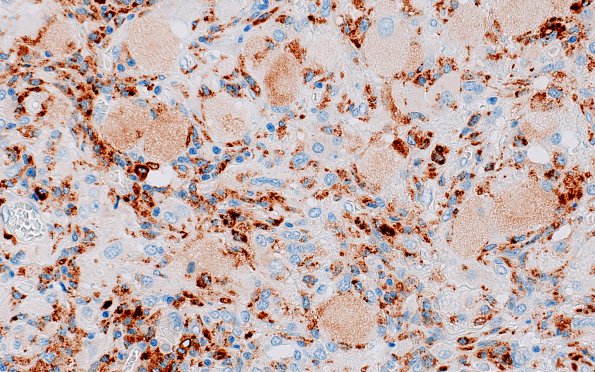
6C2 GBM, Granular Cell (Case 6) CD68 1

Table of Contents
Washington University Experience | NEOPLASMS (GLIAL) | Glioblastoma, granular cell type | 6C2 GBM, Granular Cell (Case 6) CD68 1
6C1,2 Macrophages are small and intensely stained by this lysosomal marker and tumor cells (arrow, 6C1) are large and pale (CD68 IHC)